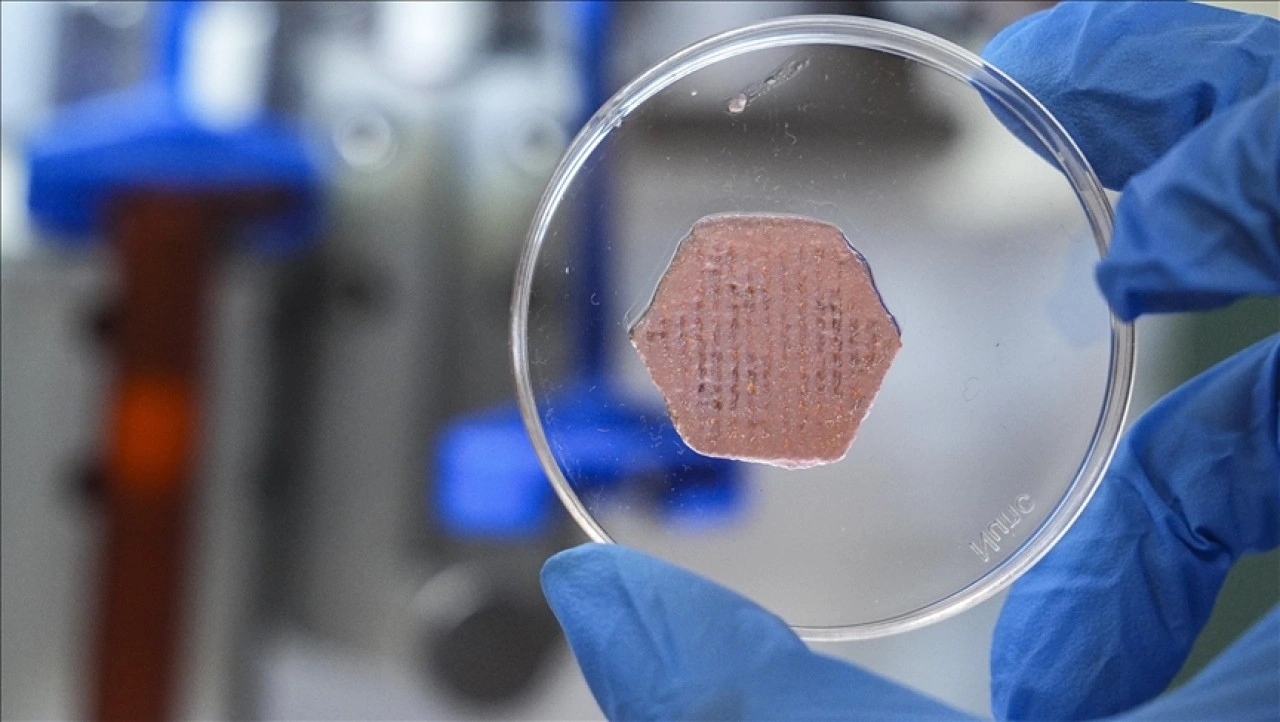

İzmir
Fen Fakültesi Kimya Bölümü Öğretim Üyesi Doç. Dr. Seda Kehr ve ekibi, kronik yaraların iyileşme sürecini hızlandırmak amacıyla yaklaşık 2 yıl önce İYTE Biyomedikal Mikro ve Nano Sistemler Laboratuvarı'nda proje çalışmaları na başladı.
????Ekibin yoğun çalışmasıyla Klasik yara bandından farklı olarak tasarlanan probiyotik içeren ürün , "Oksijen Taşıyıcı, Esansiyel Yağ ve Probiyotik Metabolitler İçeren Canlı Bir Hidrojel Bazlı Yara Örtüsü" başlığıyla Türk Patent ve Marka kurumu tarafından tescillendi.
Doç. Dr. Seda Kehr,
geliştirdikleri sistemin farklı bileşenlerin bir araya gelmesiyle sinerjik etki oluşturabilecek biçimde tasarlandığını söyledi.

Yara bantlarından farklı
Yara örtüsünün içeriğinin esansiyel (uçucu) yağlarla zenginleştirildiğini belirten Kehr, "Bizim geliştirdiğimiz yara örtüsünün en büyük özelliği içerisinde probiyotik barındırması ve aynı zamanda oksijen salınımı yapabilen bir nano parçacığa sahip olması." dedi.
Yara örtüsünün öncelikle deri hastalıkları nda kullanılmasının planlandığını ancak potansiyelinin bununla sınırlı olmadığını vurgulan Kehr, enjekte edilebilir Form sayesinde vücut içindeki yaralarda da uygulanabileceğini kaydetti.
Geliştirilen ürünün çok farklı formlarda uygulanabildiğini anlatan Kehr, "Yara örtüsü, bildiğimiz bir yara bandı gibi değil aynı zamanda püskürtülebilir ve jel olarak kullanılabilir ve üç boyutlu yazıcı baskısıyla hastaların yaralarına özel boyutlarda uygulanabilecek şekilde yaratabiliyoruz." ifadelerini kullandı.

Probiyotik içeriğiyle öne çıkıyor
Probiyotiklerin faydalı bakteriler olduğunu dile getiren Kehr, şunları kaydetti:
"Biz bu faydalı probiyotikleri yaranın gelişiminde de kullanmak istedik ve bu probiyotikleri çevresel etkilerden korumak için de onları kapsüllüyoruz. Böylelikle hem faydalı metabolitlerin salınımını kontrol altına alabiliyoruz hem yara örtüsünün ömrünü uzatabiliyoruz hem de probiyotikleri canlı bir şekilde yara örtüsünün içerisinde tutabiliyoruz."

Kehr, ürünün laboratuvar aşamasında bakteri ve hücre testlerini tamamladı klarını bir sonraki aşamada hayvan testleriyle klinik çalışmalara başlamayı planladıklarını anlattı.
Ürünün ilk etapta yarayı destekleyici formuyla piyasaya sunulmasının hedeflendiğini belirten Kehr, vücut içine uygulanabilecek biyomalzeme için klinik sürecin daha uzun zaman alacağını dile getirdi.
Kaynak: AA
dikGAZETE .com